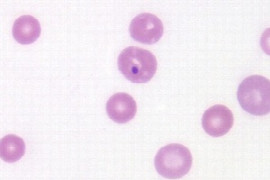
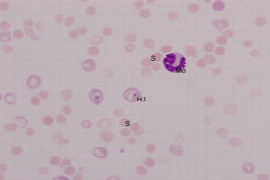

Bianka Schulz
DVM, Dipl. ECVIM-CA

Bianka Schulz
DVM, Dipl. ECVIM-CA
Bianka Schulz studierte Tiermedizin an der Ludwig-Maximilians-Universität in München, gefolgt von einer Promotion. Ihre Residency in Innere Medizin der Kleintiere im Rahmen des European College of Veterinary Internal Medicine absolvierte sie von 2001 bis 2003 an der Medizinischen Kleintierklinik der LMU München und am Small Animal Veterinary Teaching Hospital der University of Georgia in Athens (USA). Seit 2004 arbeitet sie an der Medizinischen Kleintierklinik als internistische Oberärztin. Ihr Arbeits- und Forschungsschwerpunkt liegt im Bereich der Respirationsmedizin bei Hund und Katze, mit einem besonderen Interesse für die Themengebiete infektiöser respiratorischer Erkrankungen.
Webinare

Björn Becker
DVM

Björn Becker
DVM
1972 geboren, Grundschule und Abitur im nördlichen Münsterland, Vater Tierarzt, trotzdem zunächst Ausbildung zum Kaufmann für Marketing und Kommunikation, Gründung einer Werbeagentur 1994, 2002 Studium Tiermedizin an LMU München, Abschluss 2008, Einstieg in väterliche Praxis, Übernahme der Praxis 2014, Ausbau zu 2 Standorten mit 5 Tierärzten, Zusatzqualifikationen als Chiropraktiker, zertifizierter Dry Needling Seminarleiter, Vorträge und Workshops zum Thema Social Media in der Tiermedizin, neue Kommunikationsformen und Telemedizin
Webinare

Bradley Galgut
DVM, BVSc (Hons), Diplomate ACVP

Bradley Galgut
DVM, BVSc (Hons), Diplomate ACVP
Brad graduated with honours from the University of Melbourne in 2003. He spent three years in general practice in Australia and England, before completing a three year clinical pathology residency program at Kansas State University, USA. Brad successfully passed the American College of Veterinary Pathologists board examination in Clinical Pathology in 2010 before returning to Australia. Brad worked at Gribbles Veterinary Pathology and Vepalabs Veterinary Pathology, before commencing at ASAP laboratory as pathologist and state director in 2015. His areas of interest include diagnostic cytology, haematology and biochemistry of companion animals, horses, and avian/exotic species, as well as laboratory quality management. Brad is a registered specialist in clinical pathology, a reviewer for numerous journals, and has presented at national and international conferences. He is a member of the American College of Veterinary Pathologists, the American Society for Veterinary Clinical Pathologists, the Australian Society of Veterinary Pathology, and the Australian Veterinary Association.
Webinare

DVM, Diplomate AVDC

DVM, Diplomate AVDC
Brenda graduated with her Doctor of Veterinary Medicine from Iowa State University. She entered private practice for a few years before returning to teach at Iowa State University College of Veterinary Medicine.
Dr. Mulherin completed a Dentistry and Oral Surgery Residency with the University of Wisconsin-Madison in 2014. She became a Diplomate of the American Veterinary Dental College in 2015.
Dr. Mulherin is a Full Clinical Professor at Iowa State University and is charged with small animal dentistry education for veterinary students. Recently, Dr. Mulherin was the editor of a veterinary dental radiology textbook entitled Veterinary Oral Diagnostic Imaging. This book is a compilation of imaging techniques and interpretation for companion animals, including canine, feline and equine species. It also includes information on zoo and exotic animals.
Dr. Mulherin enjoys lecturing and educating general practitioners as well as veterinary students in the art of veterinary dentistry.
Webinare

Brendan Carmel
DVM, BVSc, MVS, MANZCVSC (Unusual Pets), GDipComp

Brendan Carmel
DVM, BVSc, MVS, MANZCVSC (Unusual Pets), GDipComp
Brendan has many years experience as a veterinarian with small animals. Some career highlights include: Zoo Veterinarian for 3 years at Healesville Sanctuary, Victoria where he completed a Master of Veterinary Studies in Australian Native Wildlife, Past President (Founding President) of the Unusual & Exotic Pet Veterinarians special interest group of the Australian Veterinary Association, Lecturer in Wildlife & Unusual & Exotic Pet Medicine, The University of Melbourne, James Cook University, Townsville, Founding Member of the Association of Exotic Mammal Veterinarians, Founding Member of the Association of Reptilian & Amphibian Veterinarians, Speaker at national & international conferences, Member of the Australian College of Veterinary Scientists (Unusual Pet Medicine and Surgery), Associate Editor, Australian Veterinary Journal, Consultant in Exotic and Unusual Pets, Veterinary Clinical Centre, University of Melbourne
Webinare

Brett Stone
DVM, BVSc (Hons), BBiomedSc (Hons), M.Phil, MACVSc

Brett Stone
DVM, BVSc (Hons), BBiomedSc (Hons), M.Phil, MACVSc
Prior to commencing BVSc studies, Brett completed a Bachelor of Biomedical Sciences with Class I Honours at James Cook University, North Queensland. Brett graduated as a veterinarian from the University of QLD with Class I Honours in 2001 and worked in mixed animal practice on the outskirts of Brisbane for two years before returning to the University of QLD to undertake an internship/residency funded by QML Vetnostics in veterinary pathology. As a pathology intern Brett also concurrently undertook a research master’s project investigating the colonisation and excretion of E.coli serotype O157 in adult cattle. In 2006, after completing the internship, Brett lectured in clinical pathology at the University of QLD, was a contracted pathologist at QML Vetnostics and attained membership qualifications with the Australian College of Veterinary Scientists in Veterinary Pathology. In 2007-2008, Brett worked as a diagnostic pathologist at Cytopath Ltd in the UK, then returning to QML Vetnostics in 2008. After a brief hiatus, Brett accepted the role of supervising pathologist at Vetnostics in 2014. Brett has extensive experience in cytology and histopathology with special interest in immunohistochemistry and immunocytochemistry. In 2015, Brett successfully passed the American College of Veterinary Pathologist examinations and is a diplomat of the American College of Veterinary Pathologists in Clinical Pathology.
Webinare

Brian Beale
DVM, DACVS

Brian Beale
DVM, DACVS
Dr. Brian Beale received his D.V.M. from The University of Florida in 1985. He completed an internship at Friendship Hospital for Animals in Washington, D.C. and a surgical residency at The University of Florida. He became Board Certified by the American College of Veterinary Surgeons in 1991. Dr. Beale was an assistant professor of surgery at the University of Florida College of Veterinary Medicine prior to joining Gulf Coast Veterinary Specialists in 1992. Dr. Beale is an adjunct assistant professor at the Texas A&M College of Veterinary Medicine, and is a co-author of the industry-defining textbook, Small Animal Arthroscopy. Dr. Beale was featured in Nat Geo WILD's Animal ER in Fall 2016. Listen to Dr. Beale as he hosts Your Pet's Health on KTRH (AM 740) on Sunday nights at 8 p.m.!
Webinare

Brian Herrin
DVM, PhD, DACVM (Parasitology)

Brian Herrin
DVM, PhD, DACVM (Parasitology)
Dr. Brian Herrin is a board certified veterinary parasitologist at Kansas State University College of Veterinary Medicine. He completed both his DVM and PhD at Oklahoma State University before accepting a faculty position at Kansas State. Over the past 5 years, Dr. Herrin has been researching the use of canine serologic diagnostic tests for Lyme disease to predict the range expansion of the disease and the risk of infection to humans. While his current research focus is on the epidemiology Lyme borreliosis in humans and dogs in North America, he is always looking for new and interesting projects on ticks and tick-borne diseases. Some of his recent interests are the evaluation of diagnostic assays for tick-borne diseases and surveillance of ticks and tick-borne diseases from horses. Although his research focus is on ticks, Dr. Herrin enjoys working with all parasites of veterinary importance through the diagnostic service and teaching/outreach opportunities. If you come across any interesting or challenging parasite cases, do not hesitate to contact Dr. Herrin at the Kansas State Veterinary Diagnostic Laboratory.
Webinare

Brian Patterson
BVM&S, CertVOphthal, MRCVS

Brian Patterson
BVM&S, CertVOphthal, MRCVS
Brian graduated from Edinburgh University in 1996. After completing a two year hospital internship, he took up a 3 year ophthalmology based residency at the Weipers Centre, University of Glasgow, and whilst there was awarded the RCVS certificate in ophthalmology in 2002. For the last ten years he has worked as a veterinary ophthalmologist in the south west of England and is clinical director of the ophthalmolgoy service at Vale Referrals. As a full time clinician, Brian has been also been involved in teaching ophthalmology at the University of Bristol (2010-2012) and has lectured both nationally and internationally. Clinically, his particular areas of interest are cataract surgery and emergency eye care.
Webinare

Bronwen Bollaert
DVM, BVSc, MSc, MANZCVS (Veterinary Behaviour)

Bronwen Bollaert
DVM, BVSc, MSc, MANZCVS (Veterinary Behaviour)
Dr Bronwen completed her undergraduate veterinary training at Onderstepoort, University of Pretoria, in South Africa. Over several years she worked in small animal private practice, the Johannesburg SPCA and the Johannesburg Zoological Gardens. During her time at the JHB Zoo, Bronwen also undertook research into infectious disease in African Buffalo and completed her Master of Veterinary Science Degree by dissertation. In 2008 Dr Bronwen emigrated to Australia and returned to small animal practice whilst building additional skills in Veterinary Behaviour. Since then, Dr Bronwen has become a Member of the Veterinary Behaviour Chapter of the Australian and New Zealand College of Veterinary Science, has been the ANZCVS Science Week convenor and is the current President-elect for the Chapter. Dr Bronwen advises on an Expert Advisory Panel developing gold standard training curricula for dog trainers. Dr Bronwen owns and runs Healthy Pet Behaviour Services, providing behavioural medicine services to the Greater Brisbane area, and Healthy Pet Mobile Vet, a GP house call service in Brisbane’s North. She is actively involved in promoting awareness of mental health in animals and is excited to be able to play a part in educating clients, colleagues and the greater community about this fascinating field.
Webinare

Bronwyn Fullagar
BVSc, MS, DACVS-SA

Bronwyn Fullagar
BVSc, MS, DACVS-SA
Dr Bronwyn Fullagar is a specialist small animal surgeon based in the Canadian Rocky Mountains. She grew up in Brisbane, Australia and graduated from the University of Queensland in 2007 with a Bachelor of Veterinary Science. After working in mixed and small animal general practice in Australia and the United Kingdom, she moved to Calgary, Alberta in 2011 to undertake a rotating small animal internship. Bronwyn went on to complete a residency in small animal surgery and a Master of Science degree at the Ohio State University. She returned to Canada and was awarded Diplomate of the American College of Veterinary Surgeons in 2016. Since then, Bronwyn has worked as a specialist small animal surgeon in Canada, Australia and the United States, and has volunteered as a surgical instructor for World Vets and the Worldwide Veterinary Service. At work, she enjoys challenging soft tissue surgery cases and she loves to share her enthusiasm for surgery, helping veterinary students and practicing vets to boost their expertise and confidence. When she’s not in the clinic, you can find her in the mountains, trail running with her dog, mountain biking or backcountry skiing.
Webinare

Bronwyn Orr
BVSc, MSc, PhD, MANZCVS (Animal Welfare), GAICD

Bronwyn Orr
BVSc, MSc, PhD, MANZCVS (Animal Welfare), GAICD
Dr Bronwyn Orr completed her PhD on zoonotic diseases, with a particular focus on leptospirosis, brucellosis and coxiellosis, in pig-hunting dogs in Queensland in 2022. Outside of her research, she has a keen interest in animal welfare and veterinary matters, particularly veterinary workforce issues. She's a former President of the Australian Veterinary Association (2022-2023) and is assisting Southern Cross University with establishing their new veterinary technician and veterinary science degrees. As well as freelance consulting, Bronwyn has also recently taken over CAWSEL which provides short courses in animal welfare, ethics, and law.
Webinare

Brooke Williams
BPhty, MAnimSt (Masters Animal Studies - Physiotherapy)

Brooke Williams
BPhty, MAnimSt (Masters Animal Studies - Physiotherapy)
Brooke is a qualified Physiotherapist with post graduate qualifications (Masters in Animals Studies), and a Pilates instructor. She is amongst Australia’s leading Physiotherapists specialised in Animal Physiotherapy and the Director of Holistic Animal Physiotherapy. Currently working at North Coast Veterinary Specialists (NCVS) on the Sunshine Coast, she also directs the Physiotherapy clinics at Queensland Veterinary Specialists and Animal Referral Hospital in Brisbane. In these settings she rehabilitates a wide variety of acute and chronic conditions and enjoys providing holistic management to each of her clients. Her rehabilitation includes a comprehensive treatment with her advanced Physiotherapy manual skills, acupuncture, underwater treadmill training, laser therapy, and advice and provision of a specific home program to meet the needs of each animal. Brooke is highly motivated member of her field. She has been involved in development and teaching on APA courses for Physiotherapists. the University of LIverpool Post Grad Diploma in Veterinary Physiotherapy, and is an approved internship practice for CRI (Canine Rehabilitation Institute). She has lectured at Veterinary and APA conferences throughout Australia, and has written a chapter on Acupuncture in the latest edition of Animal Physiotherapy: Assessment Treatment and Rehabilitation of Animals (Blackwell Publishing).
Brooke always strives to provide the best quality of care for all animals, with a great deal of respect for their behaviour and condition, and aims to maximise their quality of life. She prefers to work closely with the owners of the animals to provide daily care and ongoing management, with plenty of advice and support and loves furthering the understanding of Rehabilitation amongst the Veterinary profession.
Webinare

Bruce Parry
Professor, BVSc, PhD, Diplomate ACVP, Fellow AVA

Bruce Parry
Professor, BVSc, PhD, Diplomate ACVP, Fellow AVA
Bruce is Professor emeritus at the University of Melbourne. He taught clinical pathology at the Melbourne Veterinary School for 3 decades, before 'pre-retirement' in 2013. His areas of interest include haematology, cytology, coagulation and transfusion medicine. He has a practical approach to the application of laboratory tests in the clinical setting and currently provides in-house tutorials for vets and nurses.
Webinare

Camil Stoian
DVM, Ph.D, Dipl. EVDC

Camil Stoian
DVM, Ph.D, Dipl. EVDC
Österreichs einziger Spezialist / Internationaler Fachtierarzt auf dem Gebiet der Zahnmedizin der Kleintiere. DDr. Camil Stoian ist ein doppelt approbierter Zahn- und Tierarzt und einer der wenigen europäischen Tierzahnarztspezialisten. Er bietet mehr als 16 Jahre Erfahrung auf dem Gebiet der Tier-Zahnmedizin für Behandlung und Therapie von Mund-, Kiefer- und Gesichts Krankheiten. DDr. Stoian hat zahlreiche Workshops, Seminare und Vorträge in der ganzen Welt auf dem Gebiet der Tierzahnheilkunde abgehalten. Ausbildung
- Seit Jänner 2007: Diplomate of the European Veterinary Dental College, europäischer veterinärmedizinischer Zahnfacharzt
- Okt. 02- Jän. 07: Resident EVDC Ausbildung; Veterinärmedizinische Universität Wien, Klinik für Chirurgie, Augenheilkunde und Zahnheilkunde, Zahnstation, Österreich
- Okt. 99 – Okt. 05: Universität für landwirtschaftliche Wissenschaften, Cluj, Rumänien, Fakultät für Veterinärmedizin; Department für Chirurgie, Promotion zum: Doktor der Wissenschaften (Ph.D), Thema der wissenschaftlichen Arbeit: “Personal Research in Dental Implants in Dogs”
- Oktober 2002: Promotion zum Doktor der Zahnmedizin (Dr. med. dent.); Thema der Dissertation: “The Antibiotic Susceptibility and Resistance of some Species of Streptococci Isolated from the Oral Cavity”
- Okt. 96 – Sept. 02: Iuliu Hatieganu Universität für Human Medizin und Pharmazie, Cluj, Rumänien, Fakultät für Zahnheilkunde
- Oktober 1990: Promotion zum: Doktor der Veterinärmedizin (Dr. med. vet.), Thema der Dissertation: “Morphological Characteristics of “Mangalitza” Swine, and the Necessity to Preserve this Rare Breed as a Genetic Reserve”
- Sept. 85 – Sept. 90: Universität für landwirtschaftliche Wissenschaften, Cluj, Rumänien, Fakultät für Veterinärmedizin